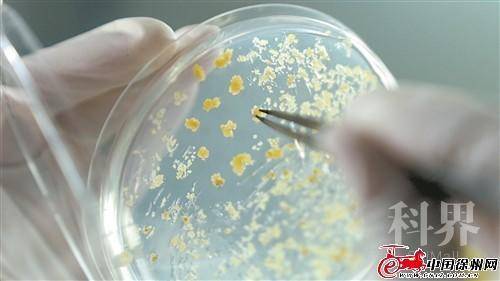
res10_attpic_brief (1).jpg

问题分诊室
打赢农业『芯片』翻身仗,徐州这样干
发布时间: 2022-01-25

贾汪区甘薯种植基地农民正在打理甘薯叶。
技术人员正在分析培养皿试验情况。
■人物介绍
杨峰:徐州市农业科学院副院长、党委委员,科研分管领导
马代夫:徐州市农业科学院二级研究员、中国作物学会甘薯专业委员会主任、国家甘薯产业技术体系原首席科学家
冯国华:国家小麦产业技术体系徐州综合试验站站长
去年7月,中央深改委第二十次会议把种源安全提升到关系国家安全的战略高度。种源为何如此重要?打赢这场种业翻身仗,徐州要怎么做?我们邀请到了三位专家一起谈一谈。
主持人:我们一直都在说种子“芯片”,种子为什么被称为“芯片”,对粮食安全有什么重要意义?
杨峰:种子是“芯片”,一是因为粮食生产主要靠良种,良种在粮食增产方面起到了关键作用;二是种质资源的多样性和丰富性保证了优异基因的创制来源,我们只有控制种源,才能确保粮食产量和质量。所以说,种子和粮食的安全是直接挂钩的,没有优质种子就生产不出来优质高产的粮食。
马代夫:民以食为天,食以农为本,农以种为先。在农业生产中,种子是解决农业生产痛难点问题、保障粮食高产优质的重要因素。如果过度依靠进口,一旦出现“断粮”的情况,那会直接影响到国家的粮食安全。我们只有抓住农业“芯片”,才能牢牢把饭碗端在自己手里。
冯国华:当前,虽然我们的粮食供给总体充足,但种业自主创新能力与发达国家相比,仍存在不小的差距,种质资源还存在着对外依赖的情形。
主持人:徐州是如何自主创新研发农业“芯片”的?研发推广成果如何?
杨峰:徐州地处南北气候过渡带,约有900多万亩耕地,自然灾害发生的较少,这也是农作物育种和种植的天然优势。
在育种方面,我们经历了几个阶段,第一个是系统选育阶段,对于育种的发展起到了重要作用。第二个是杂交育种阶段,通过亲本的选择、优良基因的聚合来选育优良品种。第三个是分子育种阶段,通过分子设计、基因分析、分子标记辅助选择等方式选育出有针对性的优良品种。通过这种育种方式,在大宗作物上,特别是在小麦和甘薯上都取得了比较好的成绩。
目前,徐麦35、徐稻9号都是我们徐州市的主推品种,徐稻9号还被江苏省列为主推品种。总体上来讲,这些品种在黄淮片区的适应性比较强,受欢迎度也很高。
马代夫:徐州在甘薯研究上一直是全国科技创新的中心。徐薯18高产稳产、高抗根腐病,被许多地区称为救命薯,是迄今为止世界上推广面积最大的甘薯品种,曾获得农业部科技进步一等奖和国家技术发明一等奖。徐薯22淀粉含量高、适应性广、产量高,在全国有十多个省还在种植,曾获农业部中华农业科技成果一等奖。现在推广潜力、应用潜力比较大的是徐紫薯8号,这个品种花青素含量比较高,适用于加工,也适用于鲜食。
冯国华:解放初期,徐麦138的推广面积达到了1000多万亩。上世纪80年代以后,徐州21、徐州24、徐州25号在黄淮南片推广面积都达到了1000万亩左右。从2008年以来,我们逐步开始应用分子技术,通过分子标记辅助手段聚合有用的基因,仅6年时间我们就育成了徐麦DH9并通过了江苏省审定。我们的小麦育种水平也在持续提高,徐州21的产量水平大概达到了500公斤,徐州856、徐麦30达到了600公斤,现在徐麦33、徐麦35的产量已经达到了700公斤至750公斤。
主持人:现在我市种业发展的难点主要体现在哪些方面?
冯国华:从小麦来说,品种多乱杂,突出的品种比较少。虽然徐州地处中强筋小麦产业带,但是难以满足各类市场需求,优质的强筋小麦还是我们育种上的弱势。
马代夫:没有好的种质资源,就育不出好的品种。每一种种质资源都蕴含着丰富的遗传多样性,优异的基因越多,越有可能结合出优质的种子,尤其体现在抗病性上。因此,只有突破种质资源的桎梏,才能培育出高产优质的种子。
杨峰:目前,我们徐州的种业企业规模普遍较小,创新能力相对较弱,缺乏必要的育种基础,尚未形成育种核心技术体系,很难担当种业科技创新的主力军。
主持人:针对这些难点,我们从哪几个方面来突破?
冯国华:随着粮食作物需求的不断变化,育种方向也在改变。徐州要围绕产业需求,不断调整育种方向,更新育种目标,深化产学研合作,有效凝聚我市的农业科技创新力量,让更多人才加入到育种工作中,培育更多优质品种。目前,我们也在不断加大新品种的试验示范,选育更多更好的品种,服务国家粮食安全、服务乡村振兴。
马代夫:要加大种质资源的收集保存和精准鉴定平台建设力度,进一步加强种质资源的保护和挖掘利用。积极建设相关作物的种质资源保存库、保存圃,不断丰富物种资源,攻克育种难关,这样才能将中国人的饭碗牢牢端在自己手中。另外,育种家也应当是一个“战略家”,要预测到10年以后的粮食市场和产业需求,有超前意识。
杨峰:要强化种业企业创新引导,出台相关激励政策,支持育种人才、资源、成果向种子企业流动,提升企业造血能力。同时,进一步加强种业知识产权保护,维护公平的种业市场秩序,激发企业创新活力,使种业企业逐步成为种业科技创新的主力军。当前,农科院也和徐州当地的种业企业联合开展了新品种选育和前期的一些技术攻关工作,帮助企业提高技术创新水平。
主持人:下一步我们在种业振兴方面还有哪些规划?
杨峰:第一是强核心技术,我们的育种还处于2.0—3.0阶段,如何达到4.0也是徐州一直在思考的。第二是强种子利用,种源是“芯片”中的“芯片”,要把我们挖掘出来的优质基因利用好。第三是强重大品种创制,虽然每年审定很多品种,但是缺少独占鳌头的重大品种。第四强单产,不仅要强理论产量,更要强实际种植产量。另外,我们还要保障种源自给率,把种源控制在自己手里,推广更适应徐州农业生产需求的重大品种。